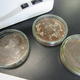

| 教育内容 Education content |
3つのコースに分かれて課題研究
課題研究では、興味や進路にあわせ選択できるようにより専門性の高い3つのコースを設定しています。
|
  |
|
|
|
 |
教育課程
専門教科の比率などをイメージできるよう、時間割の例を次に示します。総合理化学科では、わくわくするような多くの専門科目の勉強をします。

★1年次 時間割例
| 校時 | 月 | 火 | 水 | 木 | 金 |
|---|---|---|---|---|---|
| 1 | 工化 | 情数 | HR | 工化 | 体育 |
| 2 | 音楽 | 情数 | 物基 | 工基 | 言語 |
| 3 | 数Ⅰ | 実習 | 数Ⅰ | 工基 | 音楽 |
| 4 | 現国 | 実習 | 言語 | 工基 | 物基 |
| 5 | 体育 | 英CⅠ | 英CⅠ | 公共 | 英CⅠ |
| 6 | 公共 | 体育 | 保健 | 数Ⅰ | 現国 |
※年度により変更になります。赤色は専門科目の授業です。
★2年次 時間割例
| 校時 | 月 | 火 | 水 | 木 | 金 |
|---|---|---|---|---|---|
| 1 | 選Ⅰ | 体育 | HR | 工化 | 実習 |
| 2 | 選Ⅱ | 科学 | 数Ⅱ | 文国 | 実習 |
| 3 | 文国 | 英CⅡ | 実習 | 英CⅡ | 実習 |
| 4 | 数Ⅱ | 保健 | 実習 | 体育 | 科学 |
| 5 | 地総 | 地総 | 実習 | 選Ⅰ | 家庭 |
| 6 | 工化 | 工化 | 実習FW | 選Ⅱ | 家庭 |
※年度により変更になります。赤色は専門科目の授業です。(選択にも専門科目を設置しています)
★3年次 時間割例
| 校時 | 月 | 火 | 水 | 木 | 金 |
|---|---|---|---|---|---|
| 1 | 体育 | 化変 | HR | 選Ⅴ | 選Ⅲ |
| 2 | 化変 | 表記 | 体育 | 現文 | 選Ⅳ |
| 3 | 実習 | 表記 | 生基 | 生基 | 数Ⅱ |
| 4 | 実習 | C英Ⅱ | 世史 | C英Ⅱ | 課研 |
| 5 | 実習 | 選Ⅲ | 現文 | 世史 | 課研 |
| 6 | 選Ⅴ | 選Ⅳ | 数Ⅱ | 化変 | 課研 |
※年度により変更になります。赤色は専門科目の授業です。(選択にも専門科目を設置しています)
フィールドワーク学習内容

|
野外生活の知識・技術 |
地形図に関する知識 、天気図および気象の知識、テント設営、野外生活、野外での食事、アプローチおよび遭難対策、応急手当 |
| 野外生活の実践 | 移動、生活、危機管理 |
| 環境分析 | サンプリング、簡易測定、環境分析 |
| 地形、地層 | 地形と地球の活動、地層と岩石、成分分析 |
| 微生物 | 微生物と環境、採取方法、観察と分類、培養 |
| 植物 | 植物の観察、分類、標本作成、成分の抽出 |
| copyright©2020 Department of Synthesis Science and Chemistry all rights reserved. |






